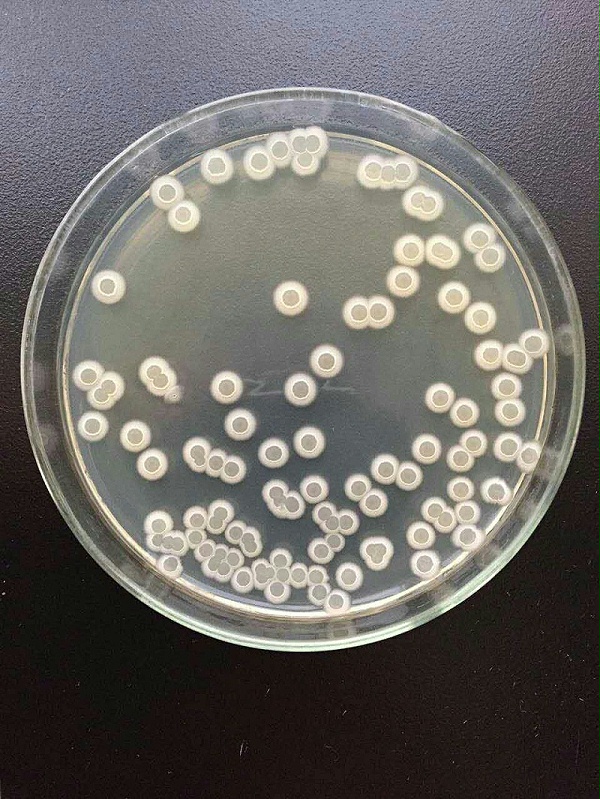
7

解淀粉芽孢杆菌用于实验和科研检测用,属于菌株类。它是一种有益菌,目前市场上主要用来生产微生物菌剂,作用机理主要包括分泌抗菌物质,产生拮抗作用,营养与空间的竞争,诱导寄主产生抗性和促进植物生长等。
1、产生低分子量抗生素以及抗菌蛋白或多肽等活性物质,抑制植物病原菌,并且可作为根围细菌促进植物生长。通过非核糖体途径合成分子量小热稳定性好、含有D-氨基酸、耐受蛋白酶水解以及有机溶剂作用的脂肽类抗生素,在生物防治应用中对植物病原细菌、真菌、病毒、线虫的抑制起到主要作用。

2、微生物通过同化作用抗菌物质抑制有害病原物的生长或发展或直接杀灭病原物。与病原菌直接作用。除了产生抗菌素等次级代谢物外,还会产生一系列对病原菌抑制起到重要作用的胞外水解酶。
3、可以迅速地抢占果蔬伤口的营养空间生长存活并大量繁殖从而抑制病害的发生。
4、植物组织在遭受机械损伤或者病原菌侵染时,体内会自发产生一系列生理生化反应来抵抗这些因素对自身的伤害。解淀粉芽孢杆菌可以诱导植物这种自然防御机能。
5、解淀粉芽孢杆菌可以产生赤霉素、吲哚乙酸、细胞分裂素等多种生理活性物质和氨基酸类物质,促进植物根系及植株生长,增强植物抗病性,从而间接地减少病害发生。

主要功效:
1、经试验证明,本品对番茄叶霉病菌、早疫病菌、灰霉病菌、黄瓜枯萎病菌、炭疽病菌、甜瓜枯萎病菌、辣椒晚疫病菌、小麦、水稻纹枯病菌、玉米小斑病菌、大豆根腐病等土传病害具有显著防效。
2、解淀粉芽孢杆菌能诱导作物产生超氧化物歧化酶(SOD),加多酚氧化酶(PPO),过氧化物酶(POD)等,提高作物抗逆性;能诱导植物快速分泌内原生长素,促进作物快速生根,提高根系发育能力,促进植物健壮生长。
3、解淀粉芽孢杆菌可改善作物根际微生态,活化土壤中难溶的磷、钾等潜在养分,改良土壤,疏松板结,遏制土壤退化,提高土壤肥力。
解淀粉芽孢杆菌可降解土壤及果实中的残留农药,减少亚硝酸盐含量,提高果蔬维生素和糖含量,改善农产品品质,提高作物产量,易贮藏运输。提高并延长肥效、减少化学肥料的用量。
